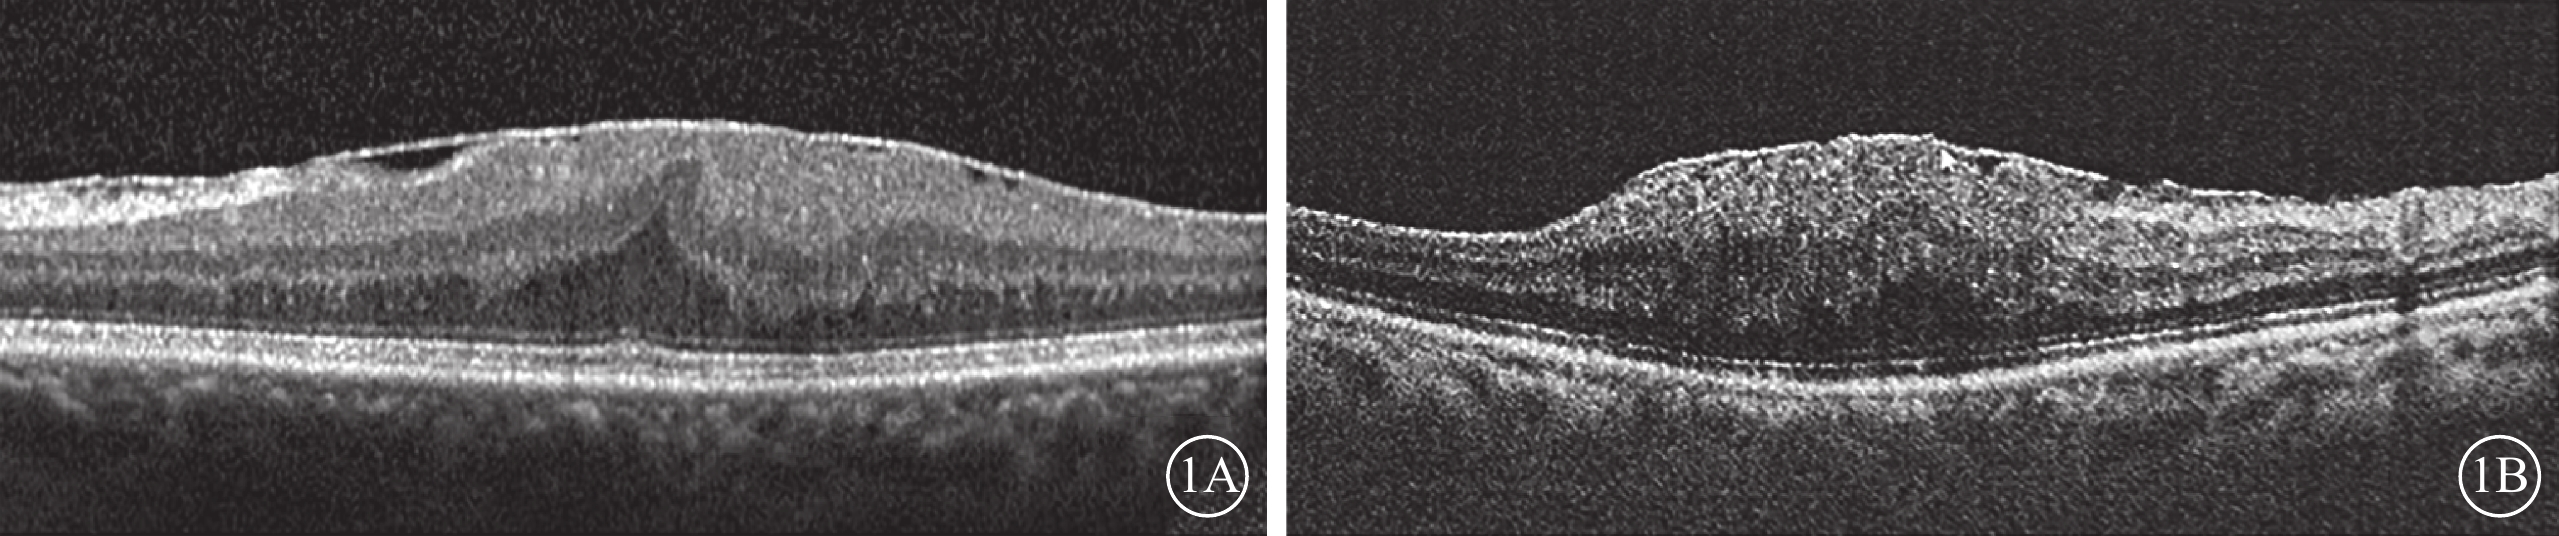

引用本文: 魏嬌婷, 劉勃實, 楊萌, 龐少芳, 聶澤彤, 張翔, 石怡, 李文博, 胡博杰. 玻璃體切割手術聯合地塞米松玻璃體腔植入劑治療重度特發性黃斑前膜的短期臨床研究. 中華眼底病雜志, 2022, 38(10): 793-798. doi: 10.3760/cma.j.cn511434-20220216-00091 復制
特發性黃斑前膜(IMEM)無明確病因,主要表現為視力下降伴視物變形。玻璃體切割手術(PPV)聯合黃斑前膜(MEM)剝除是其主要治療方式[1]。但是手術后黃斑水腫(ME)時間可長達數年[2-3]。手術后各種炎癥因子和細胞因子的釋放加劇了血視網膜屏障破壞和液體積聚,是手術后ME持續存在的主要原因[4-5]。既往研究表明,手術后ME的持續存在阻礙了黃斑區解剖結構及視功能的快速恢復[2]。地塞米松玻璃體腔植入劑(DEX)是一種皮質類固醇激素,近年已廣泛應用于視網膜靜脈阻塞繼發ME[6-7]、糖尿病ME(DME)[8]、葡萄膜炎繼發ME的治療[6-10],并獲得良好療效。此外,DEX還具有注射次數少、安全性高、藥物半衰期長、可生物降解等優點[11-12]。重度IMEM解剖結構破壞重,手術后更容易發生ME,且持續時間長[13]。目前DEX應用于重度IMEM的治療尚少[14-16]。為此,本研究采用PPV聯合DEX治療了一組重度IMEM患眼,對其手術后短期內黃斑區解剖結構及視力的變化進行了觀察分析。現將結果報道如下。
1 對象和方法
前瞻性臨床病例研究。本研究經天津醫科大學眼科醫院倫理委員會審批[批準號:2018KY(L)-17]。遵循《赫爾辛基宣言》原則,所有患者知情并簽署書面知情同意書。
2018年12月至2021年5月于天津醫科大學眼科醫院檢查確診的重度 IMEM 患者24例25只眼納入本研究。其中,男性7例7只眼,女性17例18只眼;年齡(69.208±6.467)(57~84)歲。高血壓10例;糖尿病3例。
納入標準:(1)最佳矯正視力(BCVA)下降伴或不伴視物變形;(2)眼底“錫箔樣”反光或灰白色半透明膜,頻域光相干斷層掃描(SD-OCT)檢查IMEM分期為3~4期;(3)晶狀體混濁影響眼底操作,需手術中聯合白內障超聲乳化+人工晶狀體(IOL)植入;(4)同意本研究治療方案且堅持定期隨訪。排除標準:(1)視網膜靜脈阻塞、葡萄膜炎、眼底手術等導致的繼發性MEM;(2)伴角膜混濁、角膜白斑等影響視力評估;(3)伴視網膜脫離、DME、高度近視、黃斑裂孔、青光眼等影響黃斑中心凹厚度(CMT)測量;(4)對治療有異議、不能堅持隨訪;(5)患有嚴重心、肝、腎功能不全,不能耐受手術。參照文獻[17]的標準和SD-OCT黃斑中心凹內部精細結構破壞程度將IMEM分為4期。1期:中心凹形態良好,無解剖結構紊亂;2期,中心凹陷消失,外核層增厚,但視網膜組織分層仍清晰可辨;3期:連續異位的中心凹內層視網膜結構橫跨中心凹區,視網膜組織分層仍可見(圖1A);4期:連續異位的中心凹內層視網膜結構(EIFL)橫跨中心凹區,層間結構紊亂不可辨別(圖1B)。其中,3、4期定義為重度IMEM。

患眼均行BCVA、眼壓、裂隙燈顯微鏡、間接檢眼鏡、SD-OCT檢查。BCVA檢查采用國際標準視力表進行,并將結果轉換為最小分辨角對數(logMAR)視力,手動轉化為0.005 (小數),數指轉化為0.014(小數)[18]。采用德國Heidelberg公司SD-OCT儀測量患眼CMT。采用非接觸式眼壓計測量患眼眼壓。
將患者隨機分為PPV組、PPV+DEX組,分別為11例11只眼、14例14只眼。兩組患者年齡、性別構成比、IMEM分期、logMAR BCVA、CMT以及高血壓、糖尿病患病率比較,差異均無統計學意義(P>0.05)(表1)。

所有患眼均行標準經睫狀體平坦部三通道25G PPV。手術由同一名經驗豐富的主任醫師完成。手術中均首先聯合白內障超聲乳化,曲安奈德輔助清除玻璃體及其后皮質,吲哚青綠輔助染色10 s,剝除黃斑區視網膜前膜,植入IOL。手術完畢時PPV+DEX組患眼玻璃體腔注入0.7 mg DEX。
手術后1周及1、3、6個月采用手術前相同設備和方法行相關檢查。觀察患者手術后眼部情況以及不良反應發生情況。手術后增幅ΔBCVA=logMAR手術前-logMAR手術后;降幅ΔCMT=CMT手術前-CMT手術后。
采用SPSS26.0軟件行統計學分析。年齡以均數±標準差()表示,其他計量資料以均數±標準誤差(
)表示,組間比較采用t檢驗;無序變量采用χ2檢驗或Fisher確切概率法。P<0.05為差異有統計學意義。
2 結果
與手術前比較,PPV+DEX組,手術后1周,患眼BCVA無明顯變化,差異無統計學意義(t=0.507,P=0.621);手術后1個月BCVA顯著提高,至3、6個月緩慢提高并趨于穩定,差異均有統計學意義(t= 3.974、4.639、4.453,P=0.002、P<0.001、P=0.001)。PPV組,手術后1周,患眼BCVA明顯下降,差異有統計學意義(t=-2.707,P=0.022);手術后1、3、6個月,BCVA逐漸提高,手術后1個月差異無統計學意義(t=1.579,P=0.145),手術后3、6個月差異有統計學意義(t=2.983、4.436,P=0.014、0.001)。兩組患眼手術后不同時間BCVA比較,差異均無統計學意義(P>0.05)(表2,圖2A)。PPV+DEX組、PPV組患眼手術后1周及1、3、6個月增幅ΔBCVA分別為(0.04±0.08)、(0.25±0.06)、(0.31±0.07)、(0.33±0.08)logMAR單位和(-0.28±0.10)、(0.08±0.05)、(0.15±0.05)、(0.25±0.06)logMAR單位。PPV+DEX組手術后不同時間增幅ΔBCVA均高于PPV組,其中手術后1周增幅差異最大(圖2B)。



手術后1周及1、3、6個月,PPV+DEX組、PPV組患眼CMT分別為(434.79±14.54)、(392.29±11.17)、(398.00±20.11)、(371.29±15.78) μm和(453.45±31.47)、(428.91±29.42)、(402.55±26.21)、(370.18±33.46)μm。與手術前CMT比較,PPV+DEX組,手術后1周顯著下降,手術后1個月快速下降,至3、6個月維持緩慢下降趨勢;PPV組,手術后1周、1個月無明顯降低,3個月時顯著下降,至6個月緩慢下降。兩組患眼手術后不同時間CMT比較,差異無統計學意義(t=0.538、1.164、0.140、-0.032,P=0.599、0.266、0.890、0.975)(圖3A)。PPV+DEX組、PPV組患眼手術后1周,1、3、6個月降幅ΔCMT分別為(64.36±29.63)、(106.86±36.16)、(101.14±101.69)、(127.86±109.63) μm和(14.45±13.08)、(39.00±17.96)、(65.36±21.91)、(97.73±28.24)μm。PPV+DEX組降幅ΔCMT高于PPV組,其中PPV組手術后3、6個月降幅ΔCMT逐漸接近PPV+DEX組(圖3B)。

PPV+DEX組、PPV組患眼手術前、手術后1周及1、3、6個月眼壓分別為(14.01±0.55)、(14.77±1.59)、(12.74±0.77)、(12.04±0.60)、(13.39±0.64)mm Hg(1 mm Hg=0.133 kPa)和(13.65±0.76)、(13.65±1.13)、(12.04±0.79)、(12.79±0.93)、(13.55±0.95) mm Hg。兩組患眼手術前與手術后不同時間總體眼壓比較,差異無統計學意義(F=1.639,P=0.206)。PPV組與PPV+DEX組患眼間手術前、手術后不同時間眼壓比較,差異均無統計學意義(t=-0.385、-0.544、-0.626、0.703、0.152,P=0.704、0.592、0.538、0.489、0.880)。
PPV+DEX組14只眼中,手術后1周眼壓升高(>21 mm Hg)3只眼,給予局部鹽酸卡替洛爾滴眼液治療1周,眼壓恢復正常。PPV組11只眼中,手術后1個月MEM復發1只眼;手術后6個月ME復發1只眼,給予玻璃體腔注射抗血管內皮生長因子藥物治療。
3 討論
既往文獻報道,MEM手術后ME發生率可達64%[5],其原因與MEM機械牽拉和炎癥反應有關,炎癥反應直接或間接貫穿手術前后ME發生發展的全過程[19-21]。Suzuki等[19]發現MEM的機械牽引刺激黃斑區炎癥、滲出和白細胞反應,是手術前ME的主要誘發原因;手術剝除后雖然牽引解除,但機械性剝膜導致血視網膜屏障破壞,手術后炎癥因子、細胞因子的釋放使毛細血管通透性增加,液體、蛋白質和大分子物質滲漏增強,加劇了血屏障破壞和視網膜下液體積聚[4],導致手術后持續性ME;此外,PPV本身也可誘發炎癥反應[22]。手術后持續的ME難以隨著機械牽拉的解除而自行消退[23-24],其原因主要是手術后持續的炎癥反應。
玻璃體腔注射皮質類固醇激素是加快手術后ME消退的一種可選擇治療方式。皮質類固醇激素可以阻斷血管內皮生長因子和其他炎癥介質的產生,抑制炎癥反應,增強血管內皮細胞屏障功能,減輕ME。DEX為強效抗炎的皮質類固醇激素,藥代動力學表明其在玻璃體腔內緩慢釋放可長達6個月[25],且在行PPV和未行PPV的治療眼中,DEX藥代動力學和釋放曲線相似[12]。Chang等[26]、Furino等[27]將DEX應用于MEM剝除手術后難治性ME的治療,患者手術后6個月內視力明顯改善,ME明顯消退。
本研究納入3~4期IMEM患眼,對比觀察單純PPV、PPV+DEX治療IMEM的療效,結果顯示,與手術前BCVA比較,PPV組患眼手術后1周明顯下降,1個月時無明顯變化,3個月時提高,其原因與手術中眼底機械性損傷、手術后炎癥反應重有關系;PPV+DEX組患眼手術后1周無明顯變化,但手術后1個月顯著提高,手術后早期視力增益明顯優于PPV組。同樣,在CMT較治療前變化曲線中,PPV+DEX組患眼手術后1周即明顯下降,1個月內維持快速下降趨勢;而PPV組患眼手術后6個月時其下降幅度才達到PPV+DEX組患眼1個月時的降幅。這說明DEX具有促進手術后早期黃斑解剖結構的快速恢復作用。兩組患眼手術前與手術后不同時間點BCVA、CMT比較,差異均無統計學意義,但參考差值曲線圖,可發現PPV+DEX組患眼手術后1周BCVA、CMT增益明顯優于PPV組,但不能排除由于樣本量小導致的差異無統計學意義。PPV+DEX組患眼中手術后眼壓升高3只眼,但局部給予降眼壓藥物治療后控制良好,無其他嚴重并發癥。同時我們注意到,PPV+DEX組患眼手術后3個月CMT較手術后1個月輕度增加,可能與眼內地塞米松濃度顯著下降、抗炎效果減弱有關。
DEX治療IMEM尚無定論。Guidi等[16]發現,盡管實驗組植入DEX,但在6個月時相比對照組并未表現出明顯優勢,由此作者對是否植入DEX存疑。Iovino等[14]應用PPV聯合DEX治療了一組3~4期IMEM患眼,結果顯示,DEX植入組較常規組手術后3、6個月BCVA增益更高,CMT降低更明顯,此項研究是目前少有手術前對黃斑結構進行精細分級的臨床研究。Sane等[28]發現,接受DEX治療的患眼手術后1個月BCVA較基線時增益明顯高于對照組。Savastano等[15]觀察發現,DEX植入后15 d,患眼視力較對照組明顯改善。但Guidi等[16]、Sane等[28]、Savastano等[15]研究均未對MEM進行手術前分級,因此手術前病情差異可能導致手術后統計誤差。本研究對手術前MEM進行精準分級,在國內外報道中極少。
本研究中PPV+DEX組患眼手術后早期BCVA、CMT改善優于PPV組。因此,我們認為手術中聯合DEX有助于重度IMEM患眼手術后早期視功能及解剖結構的快速恢復。但本研究存在的不足是樣本量較少、隨訪時間較短。后期我們會持續隨訪、增加觀察指標及樣本量,觀察PPV+DEX對于重度IMEM患眼長期視功能及形態學是否有明顯影響。
特發性黃斑前膜(IMEM)無明確病因,主要表現為視力下降伴視物變形。玻璃體切割手術(PPV)聯合黃斑前膜(MEM)剝除是其主要治療方式[1]。但是手術后黃斑水腫(ME)時間可長達數年[2-3]。手術后各種炎癥因子和細胞因子的釋放加劇了血視網膜屏障破壞和液體積聚,是手術后ME持續存在的主要原因[4-5]。既往研究表明,手術后ME的持續存在阻礙了黃斑區解剖結構及視功能的快速恢復[2]。地塞米松玻璃體腔植入劑(DEX)是一種皮質類固醇激素,近年已廣泛應用于視網膜靜脈阻塞繼發ME[6-7]、糖尿病ME(DME)[8]、葡萄膜炎繼發ME的治療[6-10],并獲得良好療效。此外,DEX還具有注射次數少、安全性高、藥物半衰期長、可生物降解等優點[11-12]。重度IMEM解剖結構破壞重,手術后更容易發生ME,且持續時間長[13]。目前DEX應用于重度IMEM的治療尚少[14-16]。為此,本研究采用PPV聯合DEX治療了一組重度IMEM患眼,對其手術后短期內黃斑區解剖結構及視力的變化進行了觀察分析。現將結果報道如下。
1 對象和方法
前瞻性臨床病例研究。本研究經天津醫科大學眼科醫院倫理委員會審批[批準號:2018KY(L)-17]。遵循《赫爾辛基宣言》原則,所有患者知情并簽署書面知情同意書。
2018年12月至2021年5月于天津醫科大學眼科醫院檢查確診的重度 IMEM 患者24例25只眼納入本研究。其中,男性7例7只眼,女性17例18只眼;年齡(69.208±6.467)(57~84)歲。高血壓10例;糖尿病3例。
納入標準:(1)最佳矯正視力(BCVA)下降伴或不伴視物變形;(2)眼底“錫箔樣”反光或灰白色半透明膜,頻域光相干斷層掃描(SD-OCT)檢查IMEM分期為3~4期;(3)晶狀體混濁影響眼底操作,需手術中聯合白內障超聲乳化+人工晶狀體(IOL)植入;(4)同意本研究治療方案且堅持定期隨訪。排除標準:(1)視網膜靜脈阻塞、葡萄膜炎、眼底手術等導致的繼發性MEM;(2)伴角膜混濁、角膜白斑等影響視力評估;(3)伴視網膜脫離、DME、高度近視、黃斑裂孔、青光眼等影響黃斑中心凹厚度(CMT)測量;(4)對治療有異議、不能堅持隨訪;(5)患有嚴重心、肝、腎功能不全,不能耐受手術。參照文獻[17]的標準和SD-OCT黃斑中心凹內部精細結構破壞程度將IMEM分為4期。1期:中心凹形態良好,無解剖結構紊亂;2期,中心凹陷消失,外核層增厚,但視網膜組織分層仍清晰可辨;3期:連續異位的中心凹內層視網膜結構橫跨中心凹區,視網膜組織分層仍可見(圖1A);4期:連續異位的中心凹內層視網膜結構(EIFL)橫跨中心凹區,層間結構紊亂不可辨別(圖1B)。其中,3、4期定義為重度IMEM。
患眼均行BCVA、眼壓、裂隙燈顯微鏡、間接檢眼鏡、SD-OCT檢查。BCVA檢查采用國際標準視力表進行,并將結果轉換為最小分辨角對數(logMAR)視力,手動轉化為0.005 (小數),數指轉化為0.014(小數)[18]。采用德國Heidelberg公司SD-OCT儀測量患眼CMT。采用非接觸式眼壓計測量患眼眼壓。
將患者隨機分為PPV組、PPV+DEX組,分別為11例11只眼、14例14只眼。兩組患者年齡、性別構成比、IMEM分期、logMAR BCVA、CMT以及高血壓、糖尿病患病率比較,差異均無統計學意義(P>0.05)(表1)。

所有患眼均行標準經睫狀體平坦部三通道25G PPV。手術由同一名經驗豐富的主任醫師完成。手術中均首先聯合白內障超聲乳化,曲安奈德輔助清除玻璃體及其后皮質,吲哚青綠輔助染色10 s,剝除黃斑區視網膜前膜,植入IOL。手術完畢時PPV+DEX組患眼玻璃體腔注入0.7 mg DEX。
手術后1周及1、3、6個月采用手術前相同設備和方法行相關檢查。觀察患者手術后眼部情況以及不良反應發生情況。手術后增幅ΔBCVA=logMAR手術前-logMAR手術后;降幅ΔCMT=CMT手術前-CMT手術后。
采用SPSS26.0軟件行統計學分析。年齡以均數±標準差()表示,其他計量資料以均數±標準誤差(
)表示,組間比較采用t檢驗;無序變量采用χ2檢驗或Fisher確切概率法。P<0.05為差異有統計學意義。
2 結果
與手術前比較,PPV+DEX組,手術后1周,患眼BCVA無明顯變化,差異無統計學意義(t=0.507,P=0.621);手術后1個月BCVA顯著提高,至3、6個月緩慢提高并趨于穩定,差異均有統計學意義(t= 3.974、4.639、4.453,P=0.002、P<0.001、P=0.001)。PPV組,手術后1周,患眼BCVA明顯下降,差異有統計學意義(t=-2.707,P=0.022);手術后1、3、6個月,BCVA逐漸提高,手術后1個月差異無統計學意義(t=1.579,P=0.145),手術后3、6個月差異有統計學意義(t=2.983、4.436,P=0.014、0.001)。兩組患眼手術后不同時間BCVA比較,差異均無統計學意義(P>0.05)(表2,圖2A)。PPV+DEX組、PPV組患眼手術后1周及1、3、6個月增幅ΔBCVA分別為(0.04±0.08)、(0.25±0.06)、(0.31±0.07)、(0.33±0.08)logMAR單位和(-0.28±0.10)、(0.08±0.05)、(0.15±0.05)、(0.25±0.06)logMAR單位。PPV+DEX組手術后不同時間增幅ΔBCVA均高于PPV組,其中手術后1周增幅差異最大(圖2B)。



手術后1周及1、3、6個月,PPV+DEX組、PPV組患眼CMT分別為(434.79±14.54)、(392.29±11.17)、(398.00±20.11)、(371.29±15.78) μm和(453.45±31.47)、(428.91±29.42)、(402.55±26.21)、(370.18±33.46)μm。與手術前CMT比較,PPV+DEX組,手術后1周顯著下降,手術后1個月快速下降,至3、6個月維持緩慢下降趨勢;PPV組,手術后1周、1個月無明顯降低,3個月時顯著下降,至6個月緩慢下降。兩組患眼手術后不同時間CMT比較,差異無統計學意義(t=0.538、1.164、0.140、-0.032,P=0.599、0.266、0.890、0.975)(圖3A)。PPV+DEX組、PPV組患眼手術后1周,1、3、6個月降幅ΔCMT分別為(64.36±29.63)、(106.86±36.16)、(101.14±101.69)、(127.86±109.63) μm和(14.45±13.08)、(39.00±17.96)、(65.36±21.91)、(97.73±28.24)μm。PPV+DEX組降幅ΔCMT高于PPV組,其中PPV組手術后3、6個月降幅ΔCMT逐漸接近PPV+DEX組(圖3B)。

PPV+DEX組、PPV組患眼手術前、手術后1周及1、3、6個月眼壓分別為(14.01±0.55)、(14.77±1.59)、(12.74±0.77)、(12.04±0.60)、(13.39±0.64)mm Hg(1 mm Hg=0.133 kPa)和(13.65±0.76)、(13.65±1.13)、(12.04±0.79)、(12.79±0.93)、(13.55±0.95) mm Hg。兩組患眼手術前與手術后不同時間總體眼壓比較,差異無統計學意義(F=1.639,P=0.206)。PPV組與PPV+DEX組患眼間手術前、手術后不同時間眼壓比較,差異均無統計學意義(t=-0.385、-0.544、-0.626、0.703、0.152,P=0.704、0.592、0.538、0.489、0.880)。
PPV+DEX組14只眼中,手術后1周眼壓升高(>21 mm Hg)3只眼,給予局部鹽酸卡替洛爾滴眼液治療1周,眼壓恢復正常。PPV組11只眼中,手術后1個月MEM復發1只眼;手術后6個月ME復發1只眼,給予玻璃體腔注射抗血管內皮生長因子藥物治療。
3 討論
既往文獻報道,MEM手術后ME發生率可達64%[5],其原因與MEM機械牽拉和炎癥反應有關,炎癥反應直接或間接貫穿手術前后ME發生發展的全過程[19-21]。Suzuki等[19]發現MEM的機械牽引刺激黃斑區炎癥、滲出和白細胞反應,是手術前ME的主要誘發原因;手術剝除后雖然牽引解除,但機械性剝膜導致血視網膜屏障破壞,手術后炎癥因子、細胞因子的釋放使毛細血管通透性增加,液體、蛋白質和大分子物質滲漏增強,加劇了血屏障破壞和視網膜下液體積聚[4],導致手術后持續性ME;此外,PPV本身也可誘發炎癥反應[22]。手術后持續的ME難以隨著機械牽拉的解除而自行消退[23-24],其原因主要是手術后持續的炎癥反應。
玻璃體腔注射皮質類固醇激素是加快手術后ME消退的一種可選擇治療方式。皮質類固醇激素可以阻斷血管內皮生長因子和其他炎癥介質的產生,抑制炎癥反應,增強血管內皮細胞屏障功能,減輕ME。DEX為強效抗炎的皮質類固醇激素,藥代動力學表明其在玻璃體腔內緩慢釋放可長達6個月[25],且在行PPV和未行PPV的治療眼中,DEX藥代動力學和釋放曲線相似[12]。Chang等[26]、Furino等[27]將DEX應用于MEM剝除手術后難治性ME的治療,患者手術后6個月內視力明顯改善,ME明顯消退。
本研究納入3~4期IMEM患眼,對比觀察單純PPV、PPV+DEX治療IMEM的療效,結果顯示,與手術前BCVA比較,PPV組患眼手術后1周明顯下降,1個月時無明顯變化,3個月時提高,其原因與手術中眼底機械性損傷、手術后炎癥反應重有關系;PPV+DEX組患眼手術后1周無明顯變化,但手術后1個月顯著提高,手術后早期視力增益明顯優于PPV組。同樣,在CMT較治療前變化曲線中,PPV+DEX組患眼手術后1周即明顯下降,1個月內維持快速下降趨勢;而PPV組患眼手術后6個月時其下降幅度才達到PPV+DEX組患眼1個月時的降幅。這說明DEX具有促進手術后早期黃斑解剖結構的快速恢復作用。兩組患眼手術前與手術后不同時間點BCVA、CMT比較,差異均無統計學意義,但參考差值曲線圖,可發現PPV+DEX組患眼手術后1周BCVA、CMT增益明顯優于PPV組,但不能排除由于樣本量小導致的差異無統計學意義。PPV+DEX組患眼中手術后眼壓升高3只眼,但局部給予降眼壓藥物治療后控制良好,無其他嚴重并發癥。同時我們注意到,PPV+DEX組患眼手術后3個月CMT較手術后1個月輕度增加,可能與眼內地塞米松濃度顯著下降、抗炎效果減弱有關。
DEX治療IMEM尚無定論。Guidi等[16]發現,盡管實驗組植入DEX,但在6個月時相比對照組并未表現出明顯優勢,由此作者對是否植入DEX存疑。Iovino等[14]應用PPV聯合DEX治療了一組3~4期IMEM患眼,結果顯示,DEX植入組較常規組手術后3、6個月BCVA增益更高,CMT降低更明顯,此項研究是目前少有手術前對黃斑結構進行精細分級的臨床研究。Sane等[28]發現,接受DEX治療的患眼手術后1個月BCVA較基線時增益明顯高于對照組。Savastano等[15]觀察發現,DEX植入后15 d,患眼視力較對照組明顯改善。但Guidi等[16]、Sane等[28]、Savastano等[15]研究均未對MEM進行手術前分級,因此手術前病情差異可能導致手術后統計誤差。本研究對手術前MEM進行精準分級,在國內外報道中極少。
本研究中PPV+DEX組患眼手術后早期BCVA、CMT改善優于PPV組。因此,我們認為手術中聯合DEX有助于重度IMEM患眼手術后早期視功能及解剖結構的快速恢復。但本研究存在的不足是樣本量較少、隨訪時間較短。后期我們會持續隨訪、增加觀察指標及樣本量,觀察PPV+DEX對于重度IMEM患眼長期視功能及形態學是否有明顯影響。